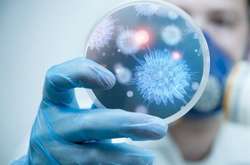
У Грузії від «свинячого грипу» померла вагітна жінка, дитину врятували

грип

Захворюваність на грип в Україні менше епідемічного порогу на 17,6%
10 сiчня, 2019 12:31

Медики закликають людей вчасно звертатися до поліклінік
10 сiчня, 2019 10:43

Епідемії у Вінницькій області ще немає
9 сiчня, 2019 21:01

За перших ознак, зокрема,дуже висока температура, необхідно негайно звертатися до лікаря за кваліфікованою допомогою, - Кухар
9 сiчня, 2019 17:40

Небезпека грипу або тяжкої застуди полягає в ускладненнях, які можуть коштувати навіть життя
9 сiчня, 2019 16:50

У Рівненській області померла 16-річна дівчина
9 сiчня, 2019 12:31

Результати за перший тиждень 2019 року
9 сiчня, 2019 07:16

Міністерство охорони здоров'я Грузії перевело п'ять клінік у Тбілісі у цілодобовий режим
8 сiчня, 2019 18:20

З початку епідсезону у Києві зареєстровано 4 летальні випадки від ускладнень після грипу
8 сiчня, 2019 13:27

У столиці за 53-й тиждень епідсезону зареєстровано 11 907 хворих на грип та ГРВІ
8 сiчня, 2019 12:58

Стан чоловіків і жінок при деяких захворюваннях відрізняється, зазначила Супрун
6 сiчня, 2019 21:45

Інформація щодо захворюваності на інфекційні хвороби в Одесі
4 сiчня, 2019 09:13

МОЗ заявляє, що епідемії грипу в країні наразі немає
3 сiчня, 2019 23:46

За тиждень зареєстровано близько 13 тисяч хворих на грип і ГРВІ
3 сiчня, 2019 00:33


В Одесі відбувається зростання захворюваності на кір, ГРВІ та грип. Вакцина від кору, паротиту та краснухи виробництва Бельгії є в наявності у всіх дитячих поліклініках
28 грудня, 2018 07:22

Епідемічні пороги перевищені у восьми областях
27 грудня, 2018 18:06

Головний інфекціоніст країни радить не чекати, відразу звертатись до лікаря, бо вже за п’ять діб можуть настати смертельні ускладнення
27 грудня, 2018 18:04

Чому вірус грипу вважається сильнішим та більш небезпечним, ніж ГРВІ? Як відрізнити симптоми грипу та ГРВІ? Коли треба викликати екстрену допомогу? Відповіді на ці та інші питання читайте далі.
27 грудня, 2018 17:09

Тепер Україна та Китай повинні узгодити вимоги та процедуру експорту вказаної продукції
26 грудня, 2018 18:49

У Києві спостерігалося зростання захворюваності у порівнянні з попереднім тижнем на 4,5%
26 грудня, 2018 09:47
Це вже друга смерть від грипу у Грузії за останній час
25 грудня, 2018 16:58

За словами Супрун, вакцинація - найбільш дієвий засіб захист від грипу
24 грудня, 2018 02:20


«Двоє людей із групи ризику померло: внаслідок вірусу грипу типу А (Н3N2) і коронавірусу», - повідомили в МОЗ
20 грудня, 2018 12:43

У Києві спостерігається зростання захворюваності на грип та ГРВІ
18 грудня, 2018 14:26

62-річна харків'янка мешкала поблизу міської поліклініки № 11, але до лікарів не зверталася, лікувалася самотужки
17 грудня, 2018 16:26

Більшість хворих на грип та ГРВІ - діти
17 грудня, 2018 11:48

Захворюваність на грип і ГРВІ перевищила епідпоріг у п’ятьох областях
14 грудня, 2018 03:31

Зафіксовано одну смерть у результаті ускладнень грипу
13 грудня, 2018 14:33
